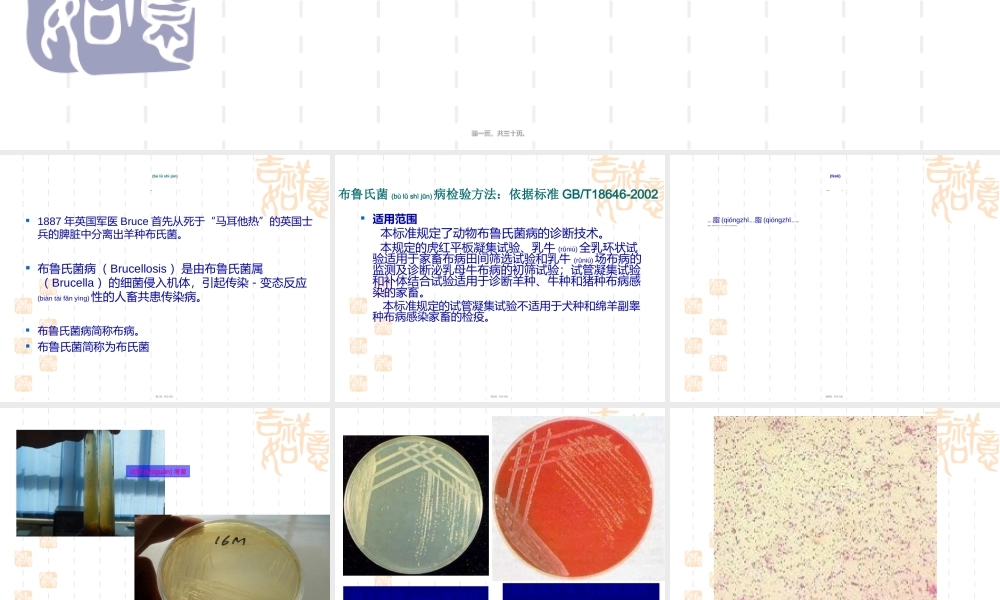
2022年医学专题—布病血清学检疫定稿.ppt

动物(dòngwù)布氏杆菌病血清学诊断第一页,共三十页。第一页,共三十页。1887年英国军医Bruce首先从死于“马耳他热”的英国士兵的脾脏中分离出羊种布氏菌。布鲁氏菌病(Brucellosis)是由布鲁氏菌属(Brucella)的细菌侵入机体,引起传染-变态反应(biàntàifǎnyìng)性的人畜共患传染病。布鲁氏菌病简称布病。布鲁氏菌简称为布氏菌布鲁氏菌(bùlǔshìjūn)病第二页,共三十页。第二页,共三十页。适用范围本标准规定了动物布鲁氏菌病的诊断技术。本规定的虎红平板凝集试验、乳牛(rǔniú)全乳环状试验适用于家畜布病田间筛选试验和乳牛(rǔniú)场布病的监测及诊断泌乳母牛布病的初筛试验;试管凝集试验和补体结合试验适用于诊断羊种、牛种和猪种布病感染的家畜。本标准规定的试管凝集试验不适用于犬种和绵羊副睾种布病感染家畜的检疫。布鲁氏菌(bùlǔshìjūn)病检验方法:依据标准GB/T18646-2002第三页,共三十页。第三页,共三十页。布氏杆菌分离(fēnlí)培养布菌培养:琼脂(qióngzhī)培养基、血琼脂(qióngzhī)培养基,厌氧培养。布菌鉴定:菌落形态观察、涂片、染色、镜检布氏菌,诊断血清凝集试验。第四页,共三十页。第四页,共三十页。试管(shìguǎn)增菌布氏菌特异布氏菌特异(tèyì)(tèyì)的油滴样菌落的油滴样菌落第五页,共三十页。第五页,共三十页。图2血平皿布氏菌菌落(jūnluò)图1琼脂(qióngzhī)布鲁氏菌菌落第六页,共三十页。第六页,共三十页。布氏菌革兰染色(rǎnsè)镜检第七页,共三十页。第七页,共三十页。布病血清学检验(jiǎnyàn)12布病虎红平板凝集(níngjí)实验布病虎红平板凝集(níngjí)实验布病试管(shìguǎn)凝集实验布病试管(shìguǎn)凝集实验第八页,共三十页。第八页,共三十页。布病虎红平板(píngbǎn)凝集实验材料准备:抗原、标准阳性血清、阴性血清由青岛易邦生物科技公司提供,按说明用。受检血清应新鲜,无明显(míngxiǎn)蛋白凝块,无溶血和无腐败气味。准备一块洁净玻璃板,画成若干个4厘米小格或虎红平板凝集试验玻璃板、陶瓷板。用移液器,适于滴加0.03ml(即300μl)液体。原理:利用酸性带色的抗原与被检血清作用时能抑制血清中的IgM类抗体的凝集活性,主要检查血清中的IgG类抗体。第九页,共三十页。第九页,共三十页。操作方法在实验薄片上标记好位置滴加0.03ml的抗原。图1.在每一个(yīɡè)标记好的布病抗原上滴加0.03ml的待检血清,...